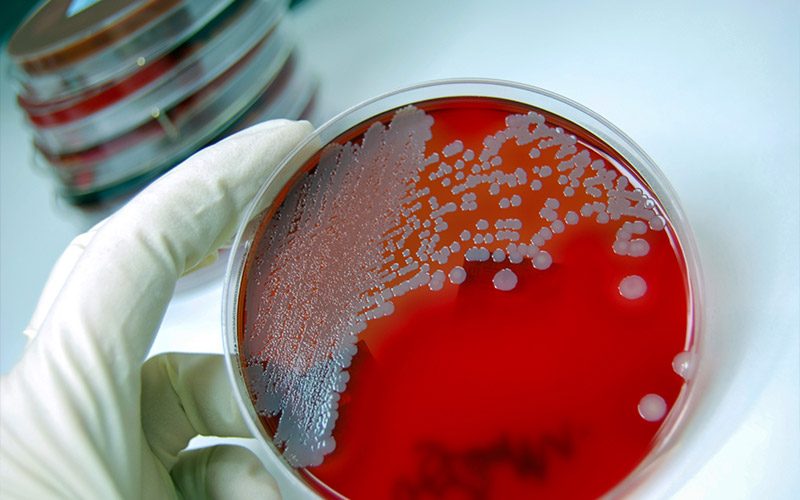
In the left, gloved hand of a researcher, is a red Petri dish.

Sex & Sensitivity to Oxygen Toxicity
There could be a link between sex and oxygen toxicity. Learn more about ongoing research into this topic.

Divers Blog Post Type
There could be a link between sex and oxygen toxicity. Learn more about ongoing research into this topic.

Jet lag is common amongst scuba divers because so many travel far distances. Here are the best recommendations to counteract jet lag and have an enjoyable trip.

Deep vein thrombosis (DVT) is a condition in which a blood clot (thrombus) forms in one or more of the deep veins, usually in the legs. DVT is not related to diving, but divers can suffer from it after long periods of travel. Read more.

Crowdsourcing is a means to raise funds through public contributions in a manner which allows a large number of small contributions to make a difference. It migrated into the research realm and has helped raise nearly a million dollars for research projects.
Heart attack symptoms manifest differently in women than men. When you understand more about heart disease and heart attacks, you are better able to stay healthy and prepared.

Cardiovascular disease acted as a disabling condition on numerous breath-hold and scuba fatalities. Learn more.

Endothelium is a single cell layer lining the inner surface of blood vessels. It plays an important role in the regulation of circulation and reaction to various kinds of stress. […]

Medicinal nicotine — chewing gums, patches, etc. — may help people quit smoking, but medical supervision is advised. For divers, there are more considerations. Learn more.

Although exercise is considered a healthy habit, it can be linked to cardiovascular events in certain populations of adults. Learn more about the role of cardiovascular events in these instances.

Physical activity is important aspect of health, but before you start a regime, complete a questionnaire to determine if and when you should talk to your doctor.
